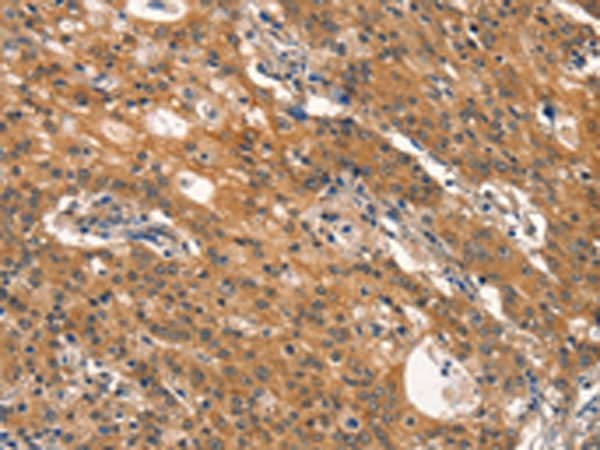

别名:DYN2; CMT2M; DYNII; LCCS5; CMTDI1; CMTDIB; DI-CMTB应用:WB,IHC
反应种属:Human, Mouse, Rat
规格:50μl/100μl
| Description |
|---|
| Dynamins represent one of the subfamilies of GTP-binding proteins. These proteins share considerable sequence similarity over the N-terminal portion of the molecule, which contains the GTPase domain. Dynamins are associated with microtubules. They have been implicated in cell processes such as endocytosis and cell motility, and in alterations of the membrane that accompany certain activities such as bone resorption by osteoclasts. Dynamins bind many proteins that bind actin and other cytoskeletal proteins. Dynamins can also self-assemble, a process that stimulates GTPase activity. Five alternatively spliced transcripts encoding different proteins have been described. |
| Specification | |
|---|---|
| Aliases | DYN2; CMT2M; DYNII; LCCS5; CMTDI1; CMTDIB; DI-CMTB |
| Swissprot | P50570 |
| WB Predicted band size | 98 kDa |
| Host/Isotype | Rabbit IgG |
| Storage | Store at 4°C short term. Aliquot and store at -20°C long term. Avoid freeze/thaw cycles. |
| Species Reactivity | Human, Mouse, Rat |
| Immunogen | Synthetic peptide of human DNM2 |
| Formulation | pH7.4 PBS, 0.05% NaN3, 40% Glycerol |
| Application | |
|---|---|
| WB | 1/500-1/2000 |
| IHC | 1/50-1/200 |
| ELISA | 1/2000-1/5000 |
![]() |
Gel: 6%SDS-PAGE, Lysate: 40 μg, Lane 1-3: Hela cells, NIH/3T3 cells, Raji cells, Primary antibody: P04840(DNM2 Antibody) at dilution 1/400, Secondary antibody: Goat anti rabbit IgG at 1/8000 dilution, Exposure time: 30 seconds |
![]() |
The image is immunohistochemistry of paraffin-embedded Human gasrtic cancer tissue using P04840(DNM2 Antibody) at dilution 1/40. (Original magnification: ×200) |
![]() |
The image is immunohistochemistry of paraffin-embedded Human thyroid cancer tissue using P04840(DNM2 Antibody) at dilution 1/40. (Original magnification: ×200) |
本公司的所有产品仅用于科学研究或者工业应用等非医疗目的,不可用于人类或动物的临床诊断或治疗,非药用,非食用。
暂无评论
本公司的所有产品仅用于科学研究或者工业应用等非医疗目的,不可用于人类或动物的临床诊断或治疗,非药用,非食用。
中文

发表回复